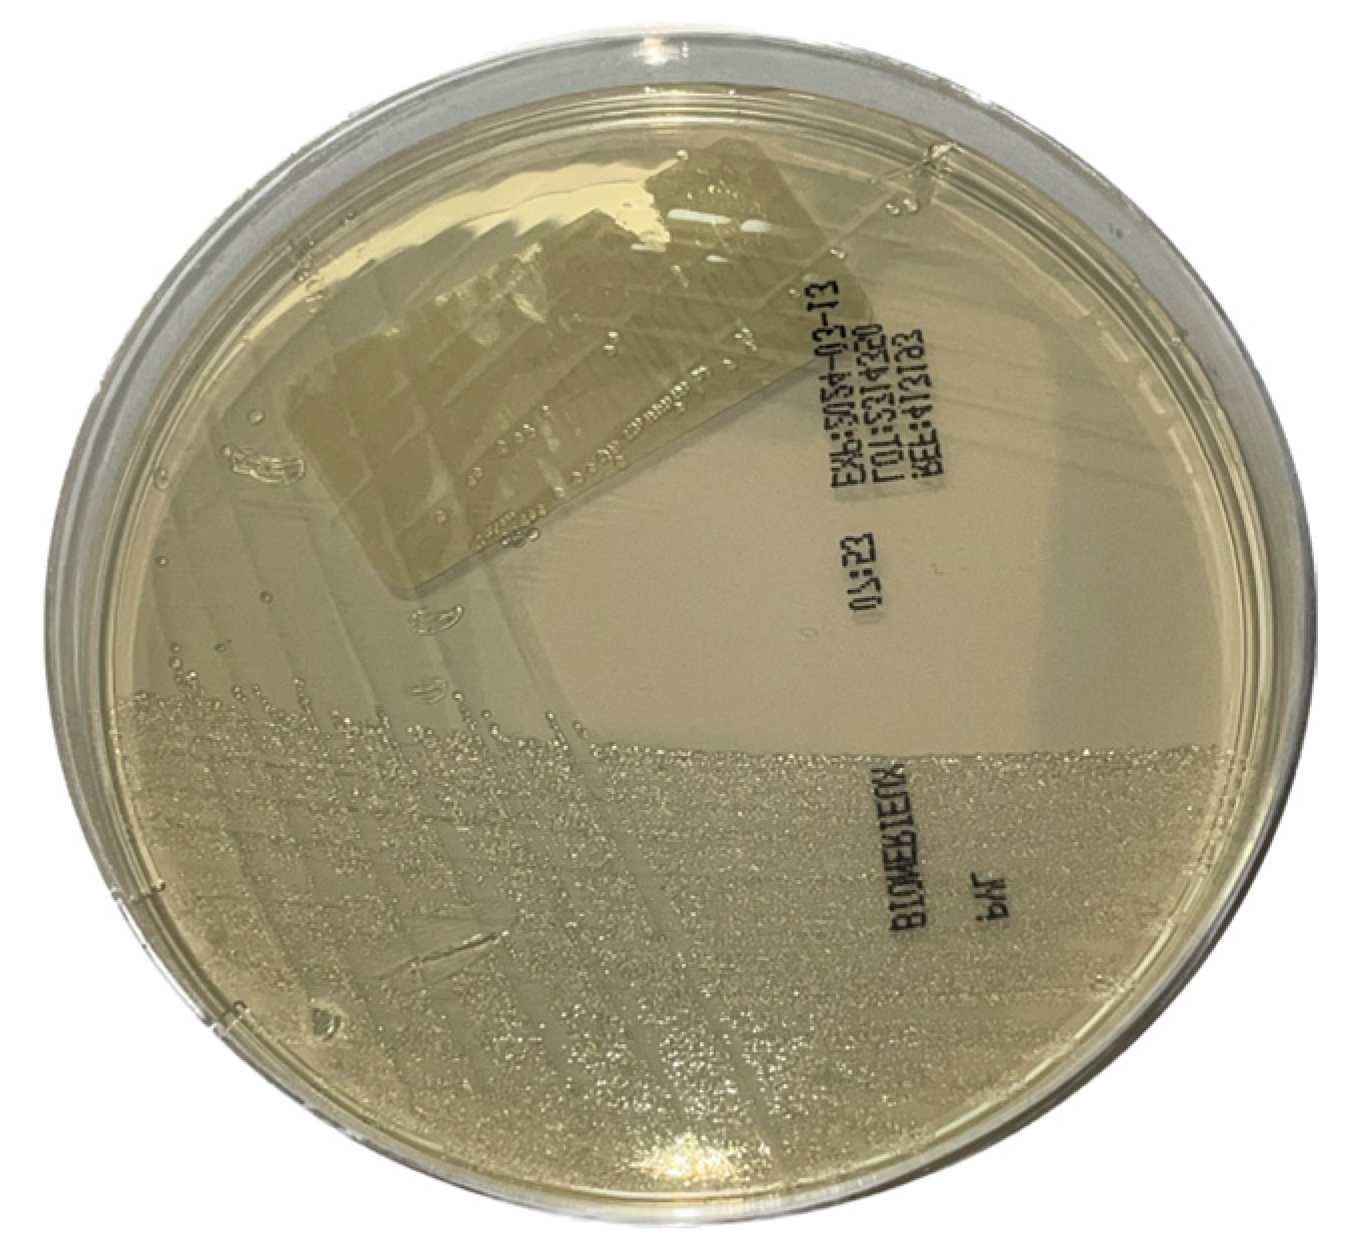
Microorganisms 12 02192 g001

Detection by Real-Time PCR of Helicobacter pylori and Clarithromycin Resistance Compared to Histology on Gastric Biopsies
Abstract
:1. Introduction
2. Materials and Methods
2.1. Biopsies Collection
2.2. Real-Time PCR
2.3. Bacterial Culture
2.4. Antibiotic Susceptibility Testing (AST)
2.5. Histological Analysis
2.6. Statistical Analysis
3. Results
3.1. Method Validation
3.2. Routine Evaluation
4. Discussion
5. Conclusions
Author Contributions
Funding
Data Availability Statement
Conflicts of Interest
References
- Chmiela, M.; Karwowska, Z.; Gonciarz, W.; Allushi, B.; Stączek, P. Host pathogen interactions in Helicobacter pylori related gastric cancer. World J. Gastroenterol. 2017, 23, 1521–1540. [Google Scholar] [CrossRef] [PubMed]
- Kusters, J.G.; van Vliet, A.H.; Kuipers, E.J. Pathogenesis of Helicobacter pylori infection. Clin. Microbiol. Rev. 2006, 19, 449–490. [Google Scholar] [CrossRef] [PubMed]
- de Martel, C.; Georges, D.; Bray, F.; Ferlay, J.; Clifford, G.M. Global burden of cancer attributable to infections in 2018: A worldwide incidence analysis. Lancet Glob. Health 2020, 8, e180–e190. [Google Scholar] [CrossRef] [PubMed]
- ARC Working Group; World Health Organization; International Agency for Research on Cancer. IARC Monographs on the Evaluation of Carcinogenic Risks to Humans. Schistosomes, Liver Flukes and Helicobacter pylori; International Agency for Research on Cancer: Lyon, France, 1994; Volume 61, pp. 177–240. [Google Scholar]
- Ford, A.C.; Yuan, Y.; Forman, D.; Hunt, R.; Moayyedi, P. Helicobacter pylori eradication for the prevention of gastric neoplasia. Cochrane Database Syst. Rev. 2020, 7, CD005583. [Google Scholar] [CrossRef] [PubMed]
- Duan, F.; Song, C.; Zhang, J.; Wang, P.; Ye, H.; Dai, L.; Zhang, J.; Wang, K. Evaluation of the Epidemiologic Efficacy of Eradicating Helicobacter pylori on Development of Gastric Cancer. Epidemiol. Rev. 2019, 41, 97–108. [Google Scholar] [CrossRef]
- Doorakkers, E.; Lagergren, J.; Engstrand, L.; Brusselaers, N. Eradication of Helicobacter pylori and Gastric Cancer: A Systematic Review and Meta-analysis of Cohort Studies. J. Natl. Cancer Inst. 2016, 108, djw132. [Google Scholar] [CrossRef]
- Ford, A.C.; Yuan, Y.; Moayyedi, P. Helicobacter pylori eradication therapy to prevent gastric cancer: Systematic review and meta-analysis. Gut 2020, 69, 2113–2121. [Google Scholar] [CrossRef]
- Roberts, S.E.; Morrison-Rees, S.; Samuel, D.G.; Thorne, K.; Akbari, A.; Williams, J.G. Review article: The prevalence of Helicobacter pylori and the incidence of gastric cancer across Europe. Aliment. Pharmacol. Ther. 2016, 43, 334–345. [Google Scholar] [CrossRef]
- Hooi, J.K.Y.; Lai, W.Y.; Ng, W.K.; Suen, M.M.Y.; Underwood, F.E.; Tanyingoh, D.; Malfertheiner, P.; Graham, D.Y.; Wong, V.W.S.; Wu, J.C.Y.; et al. Global Prevalence of Helicobacter pylori Infection: Systematic Review and Meta-Analysis. Gastroenterology 2017, 153, 420–429. [Google Scholar] [CrossRef]
- Sjomina, O.; Pavlova, J.; Niv, Y.; Leja, M. Epidemiology of Helicobacter pylori infection. Helicobacter 2018, 23 (Suppl. S1), e12514. [Google Scholar] [CrossRef]
- Sung, H.; Ferlay, J.; Siegel, R.L.; Laversanne, M.; Soerjomataram, I.; Jemal, A.; Bray, F. Global Cancer Statistics 2020: GLOBOCAN Estimates of Incidence and Mortality Worldwide for 36 Cancers in 185 Countries. CA Cancer J. Clin. 2021, 71, 209–249. [Google Scholar] [CrossRef] [PubMed]
- International Agency for Research on Cancer Helicobacter Pylori Working Group. Helicobacter pylori Eradication as a Strategy for Preventing Gastric Cancer; IARC Working Group Reports, No. 8; International Agency for Research on Cancer: Lyon, France, 2014; Available online: http://www.iarc.fr/en/publications/pdfsonline/wrk/wrk8/index.php (accessed on 4 April 2024).
- Kato, M.; Ota, H.; Okuda, M.; Kikuchi, S.; Satoh, K.; Shimoyama, T.; Suzuki, H.; Handa, O.; Furuta, T.; Mabe, K.; et al. Guidelines for the management of Helicobacter pylori infection in Japan: 2016 Revised Edition. Helicobacter 2019, 24, e12597. [Google Scholar] [CrossRef] [PubMed]
- Megraud, F.; Bruyndonckx, R.; Coenen, S.; Wittkop, L.; Huang, T.D.; Hoebeke, M.; Bénéjat, L.; Lehours, P.; Goossens, H.; Glupczynski, Y.; et al. Helicobacter pylori resistance to antibiotics in Europe in 2018 and its relationship to antibiotic consumption in the community. Gut 2021, 70, 1815–1822. [Google Scholar] [CrossRef] [PubMed]
- Malfertheiner, P.; Bazzoli, F.; Delchier, J.C.; Celiñski, K.; Giguère, M.; Rivière, M.; Mégraud, F.; Pylera Study Group. Helicobacter pylori eradication with a capsule containing bismuth subcitrate potassium, metronidazole, and tetracycline given with omeprazole versus clarithromycin-based triple therapy: A randomised, open-label, non-inferiority, phase 3 trial. Lancet 2011, 377, 905–913, Erratum in Lancet 2011, 378, 1778. [Google Scholar] [CrossRef]
- Stone, G.G.; Shortridge, D.; Flamm, R.K.; Versalovic, J.; Beyer, J.; Idler, K.; Zulawinski, L.; Tanaka, S.K. Identification of a 23S rRNA gene mutation in clarithromycin-resistant Helicobacter pylori. Helicobacter 1996, 1, 227–228. [Google Scholar] [CrossRef]
- Versalovic, J.; Osato, M.S.; Spakovsky, K.; Dore, M.P.; Reddy, R.; Stone, G.G.; Shortridge, D.; Flamm, R.K.; Tanaka, S.K.; Graham, D.Y. Point mutations in the 23S rRNA gene of Helicobacter pylori associated with different levels of clarithromycin resistance. J. Antimicrob. Chemother. 1997, 40, 283–286. [Google Scholar] [CrossRef]
- Taylor, D.E.; Ge, Z.; Purych, D.; Lo, T.; Hiratsuka, K. Cloning and sequence analysis of two copies of a 23S rRNA gene from Helicobacter pylori and association of clarithromycin resistance with 23S rRNA mutations. Antimicrob. Agents Chemother. 1997, 41, 2621–2628. [Google Scholar] [CrossRef]
- Anis, S.; Farooqi, S.R.; Niaz, S.K. Characterization of Domain V Mutations in Clinical Isolates of Helicobacter pylori in Pakistan and Their Effect on Clarithromycin MIC. Infect. Drug Resist. 2021, 14, 3393–3403. [Google Scholar] [CrossRef]
- Mégraud, F. H. pylori antibiotic resistance: Prevalence, importance, and advances in testing. Gut 2004, 53, 1374–1384. [Google Scholar] [CrossRef]
- Marques, A.T.; Vítor, J.M.B.; Santos, A.; Oleastro, M.; Vale, F.F. Trends in Helicobacter pylori resistance to clarithromycin: From phenotypic to genomic approaches. Microb. Genom. 2020, 6, e000344. [Google Scholar] [CrossRef]
- Hao, Q.; Li, Y.; Zhang, Z.J.; Liu, Y.; Gao, H. New mutation points in 23S rRNA gene associated with Helicobacter pylori resistance to clarithromycin in northeast China. World J. Gastroenterol. 2004, 10, 1075–1077. [Google Scholar] [CrossRef] [PubMed]
- Kocazeybek, B.; Sakli, M.K.; Yuksel, P.; Demirci, M.; Caliskan, R.; Sarp, T.Z.; Saribas, S.; Demiryas, S.; Kalayci, F.; Cakan, H.; et al. Comparison of new and classical point mutations associated with clarithromycin resistance in Helicobacter pylori strains isolated from dyspeptic patients and their effects on phenotypic clarithromycin resistance. J. Med. Microbiol. 2019, 68, 566–573. [Google Scholar] [CrossRef] [PubMed]
- Francesco, V.D.; Zullo, A.; Hassan, C.; Giorgio, F.; Rosania, R.; Ierardi, E. Mechanisms of Helicobacter pylori antibiotic resistance: An updated appraisal. World J. Gastrointest. Pathophysiol. 2011, 2, 35–41. [Google Scholar] [CrossRef] [PubMed]
- Gisbert, J.P. Empirical or susceptibility-guided treatment for Helicobacter pylori infection? A comprehensive review. Ther. Adv. Gastroenterol. 2020, 13, 1756284820968736. [Google Scholar] [CrossRef] [PubMed]
- Liou, J.M.; Chen, C.C.; Chang, C.M.; Fang, Y.J.; Bair, M.J.; Chen, P.Y.; Chang, C.Y.; Hsu, Y.C.; Chen, M.J.; Chen, C.C.; et al. Long-term changes of gut microbiota, antibiotic resistance, and metabolic parameters after Helicobacter pylori eradication: A multicentre, open-label, randomised trial. Lancet Infect. Dis. 2019, 19, 1109–1120. [Google Scholar] [CrossRef] [PubMed]
- Malfertheiner, P.; Megraud, F.; Rokkas, T.; Gisbert, J.P.; Liou, J.M.; Schulz, C.; Gasbarrini, A.; Hunt, R.H.; Leja, M.; O’Morain, C.; et al. Management of Helicobacter pylori infection: The Maastricht VI/Florence consensus report. Gut 2022, 71, 1724–1762. [Google Scholar] [CrossRef]
- Bénéjat, L.; Ducournau, A.; Lehours, P.; Mégraud, F. Real-time PCR for Helicobacter pylori diagnosis. The best tools available. Helicobacter 2018, 23, e12512. [Google Scholar] [CrossRef]
- Skrebinska, S.; Mégraud, F.; Bessède, E. Diagnosis of Helicobacter pylori infection. Helicobacter 2018, 23 (Suppl. S1), e12515. [Google Scholar] [CrossRef]
- Patel, S.K.; Pratap, C.B.; Jain, A.K.; Gulati, A.K.; Nath, G. Diagnosis of Helicobacter pylori: What should be the gold standard? World J. Gastroenterol. 2014, 20, 12847–12859. [Google Scholar] [CrossRef]
- Dore, M.P.; Pes, G.M. What Is New in Helicobacter pylori Diagnosis. An Overview. J. Clin. Med. 2021, 10, 2091. [Google Scholar] [CrossRef]
- Antimicrobial Resistance of Helicobacter pylori in Belgium: 2020 Update; National Reference Center for Helicobacter pylori CHU UCL Namur: Brussels, Belgium, 2020; pp. 1–5.
- Savoldi, A.; Carrara, E.; Graham, D.Y.; Conti, M.; Tacconelli, E. Prevalence of Antibiotic Resistance in Helicobacter pylori: A Systematic Review and Meta-analysis in World Health Organization Regions. Gastroenterology 2018, 155, 1372–1382.e17. [Google Scholar] [CrossRef] [PubMed]
- Ren, S.; Cai, P.; Liu, Y.; Wang, T.; Zhang, Y.; Li, Q.; Gu, Y.; Wei, L.; Yan, C.; Jin, G. Prevalence of Helicobacter pylori infection in China: A systematic review and meta-analysis. J. Gastroenterol. Hepatol. 2022, 37, 464–470. [Google Scholar] [CrossRef] [PubMed]
- Chen, Y.C.; Malfertheiner, P.; Yu, H.T.; Kuo, C.L.; Chang, Y.Y.; Meng, F.T.; Wu, Y.X.; Hsiao, J.L.; Chen, M.J.; Lin, K.P.; et al. Global Prevalence of Helicobacter pylori Infection and Incidence of Gastric Cancer between 1980 and 2022. Gastroenterology 2024, 166, 605–619. [Google Scholar] [CrossRef] [PubMed]
- Ansari, S.; Yamaoka, Y. Helicobacter pylori Infection, Its Laboratory Diagnosis, and Antimicrobial Resistance: A Perspective of Clinical Relevance. Clin. Microbiol. Rev. 2022, 35, e0025821. [Google Scholar] [CrossRef] [PubMed]
- Garcés-Duran, R.; Kindt, S.; Kotilea, K.; François, S.; Rasschaert, G.; Smet, A.; Hauser, B.; Driessen, A.; Nkuize, M.; Burette, A.; et al. Belgian consensus for Helicobacter pylori management 2023. Acta Gastroenterol. Belg. 2023, 86, 74–91. [Google Scholar] [CrossRef]
- Leszczyńska, K.; Namiot, A.; Namiot, Z.; Leszczyńska, J.K.; Jakoniuk, P.; Chilewicz, M.; Namiot, D.B.; Kemona, A.; Milewski, R.; Bucki, R. Patient factors affecting culture of Helicobacter pylori isolated from gastric mucosal specimens. Adv. Med. Sci. 2010, 55, 161–166. [Google Scholar] [CrossRef]
- Lee, J.Y.; Kim, N. Diagnosis of Helicobacter pylori by invasive test: Histology. Ann. Transl. Med. 2015, 3, 10. [Google Scholar] [CrossRef]
- Laine, L.; Lewin, D.N.; Naritoku, W.; Cohen, H. Prospective comparison of H&E, Giemsa, and Genta stains for the diagnosis of Helicobacter pylori. Gastrointest. Endosc. 1997, 45, 463–467. [Google Scholar] [CrossRef]
- Fallone, C.A.; Loo, V.G.; Lough, J.; Barkun, A.N. Hematoxylin and eosin staining of gastric tissue for the detection of Helicobacter pylori. Helicobacter 1997, 2, 32–35. [Google Scholar] [CrossRef]
- Lash, R.H.; Genta, R.M. Routine Anti-Helicobacter Immunohistochemical Staining is Significantly Superior to Reflex Staining Protocols for the Detection of Helicobacter in Gastric Biopsy Specimens. Helicobacter 2016, 21, 581–585. [Google Scholar] [CrossRef]
- Loharamtaweethong, K.; Puripat, N. Comparison of immunohistochemistry and conventional stains for Helicobacter pylori detection in gastric biopsies of patients receiving proton pump inhibitors. J. Health Sci. Med. Res. 2020, 38, 321–330. [Google Scholar] [CrossRef]
- Lascols, C.; Lamarque, D.; Costa, J.M.; Copie-Bergman, C.; Le Glaunec, J.M.; Deforges, L.; Soussy, C.J.; Petit, J.C.; Delchier, J.C.; Tankovic, J. Fast and accurate quantitative detection of Helicobacter pylori and identification of clarithromycin resistance mutations in H. pylori isolates from gastric biopsy specimens by real-time PCR. J. Clin. Microbiol. 2003, 41, 4573–4577. [Google Scholar] [CrossRef] [PubMed]
- Ramírez-Lázaro, M.J.; Lario, S.; Casalots, A.; Sanfeliu, E.; Boix, L.; García-Iglesias, P.; Sánchez-Delgado, J.; Montserrat, A.; Bella-Cueto, M.R.; Gallach, M.; et al. Real-time PCR improves Helicobacter pylori detection in patients with peptic ulcer bleeding. PLoS ONE 2011, 6, e20009. [Google Scholar] [CrossRef] [PubMed]
- Castaneda, C.A.; Castillo, M.; Sanchez, J.; Casavilca, S.; Sanchez, J.; ABernabe, L.; Suarez, N.; Chavez, I.; Ruiz, E.; Tello, K.; et al. Detection of Helicobacter pylori in gastric cancer tissue through histopathology, immunohistochemistry and real-time reverse transcription-PCR. Future Microbiol. 2020, 15, 1131–1137. [Google Scholar] [CrossRef]
- de Martel, C.; Plummer, M.; van Doorn, L.J.; Vivas, J.; Lopez, G.; Carillo, E.; Peraza, S.; Muñoz, N.; Franceschi, S. Comparison of polymerase chain reaction and histopathology for the detection of Helicobacter pylori in gastric biopsies. Int. J. Cancer 2010, 126, 1992–1996. [Google Scholar] [CrossRef]
- Ducournau, A.; Bénéjat, L.; Sifré, E.; Bessède, E.; Lehours, P.; Mégraud, F. Helicobacter pylori resistance to antibiotics in 2014 in France detected by phenotypic and genotypic methods. Clin. Microbiol. Infect. 2016, 22, 715–718. [Google Scholar] [CrossRef]
- Nezami, B.G.; Jani, M.; Alouani, D.; Rhoads, D.D.; Sadri, N. Helicobacter pylori Mutations Detected by Next-Generation Sequencing in Formalin-Fixed, Paraffin-Embedded Gastric Biopsy Specimens Are Associated with Treatment Failure. J. Clin. Microbiol. 2019, 57, e01834-18. [Google Scholar] [CrossRef]
- Hindson, C.M.; Chevillet, J.R.; Briggs, H.A.; Gallichotte, E.N.; Ruf, I.K.; Hindson, B.J.; Vessella, R.L.; Tewari, M. Absolute quantification by droplet digital PCR versus analog real-time PCR. Nat. Methods 2013, 10, 1003–1005. [Google Scholar] [CrossRef]
- Sun, L.; Talarico, S.; Yao, L.; He, L.; Self, S.; You, Y.; Zhang, H.; Zhang, Y.; Guo, Y.; Liu, G.; et al. Droplet Digital PCR-Based Detection of Clarithromycin Resistance in Helicobacter pylori Isolates Reveals Frequent Heteroresistance. J. Clin. Microbiol. 2018, 56, e00019-18. [Google Scholar] [CrossRef]
- Talarico, S.; Korson, A.S.; Leverich, C.K.; Park, S.; Jalikis, F.G.; Upton, M.P.; Broussard, E.; Salama, N.R. High prevalence of Helicobacter pylori clarithromycin resistance mutations among Seattle patients measured by droplet digital PCR. Helicobacter 2018, 23, e12472. [Google Scholar] [CrossRef]
- Ramírez-Lázaro, M.J.; Lario, S.; Quílez, M.E.; Montserrat, A.; Bella, M.R.; Junquera, F.; García-Martínez, L.; Casalots, À.; Parra, T.; Calvet, X. Droplet Digital PCR Detects Low-Density Infection in a Significant Proportion of Helicobacter pylori-Negative Gastric Biopsies of Dyspeptic Patients. Clin. Transl. Gastroenterol. 2020, 11, e00184. [Google Scholar] [CrossRef] [PubMed]
- Yan, K.; Wang, X.; Han, Y.; Tian, Y.; Niu, M.; Dong, X.; Li, X.; Li, H.; Sun, Y. Simultaneous Detection of Helicobacter pylori and Clarithromycin Resistance Mutations Using RAA-CRISPR/Cas13a Assay. Infect. Drug Resist. 2024, 17, 3001–3010. [Google Scholar] [CrossRef] [PubMed]
- Ishino, Y.; Krupovic, M.; Forterre, P. History of CRISPR-Cas from Encounter with a Mysterious Repeated Sequence to Genome Editing Technology. J. Bacteriol. 2018, 200, e00580-17. [Google Scholar] [CrossRef] [PubMed]
- Qiu, E.; Jin, S.; Xiao, Z.; Chen, Q.; Wang, Q.; Liu, H.; Xie, C.; Chen, C.; Li, Z.; Han, S. CRISPR-based detection of Helicobacter pylori in stool samples. Helicobacter 2021, 26, e12828. [Google Scholar] [CrossRef]
- Xuan, S.H.; Wu, L.P.; Zhou, Y.G.; Xiao, M.B. Detection of clarithromycin-resistant Helicobacter pylori in clinical specimens by molecular methods: A review. J. Glob. Antimicrob. Resist. 2016, 4, 35–41. [Google Scholar] [CrossRef]
- Chen, D.; Cunningham, S.A.; Cole, N.C.; Kohner, P.C.; Mandrekar, J.N.; Patel, R. Phenotypic and Molecular Antimicrobial Susceptibility of Helicobacter pylori. Antimicrob. Agents Chemother. 2017, 61, e02530-16. [Google Scholar] [CrossRef]
- Tamayo, E.; Montes, M.; Fernández-Reyes, M.; Lizasoain, J.; Ibarra, B.; Mendarte, U.; Zapata, E.; Mendiola, J.; Pérez-Trallero, E. Clarithromycin resistance in Helicobacter pylori and its molecular determinants in Northern Spain, 2013–2015. J. Glob. Antimicrob. Resist. 2017, 9, 43–46. [Google Scholar] [CrossRef]
- Sanches, B.S.; Martins, G.M.; Lima, K.; Cota, B.; Moretzsohn, L.D.; Ribeiro, L.T.; Breyer, H.P.; Maguilnik, I.; Maia, A.B.; Rezende-Filho, J.; et al. Detection of Helicobacter pylori resistance to clarithromycin and fluoroquinolones in Brazil: A national survey. World J. Gastroenterol. 2016, 22, 7587–7594. [Google Scholar] [CrossRef]

| Samples (n = 232) | RT-PCR + | RT-PCR − |
|---|---|---|
| Culture + | 29 (12.5%) | 0 (0%) |
| Culture − | 8 (3.4%) | 195 (84.05%) |
| Samples (n = 232) | RT-PCR CLR + | RT-PCR CLR − |
|---|---|---|
| E-test clarithromycin resistant | 7 (18.9%) | 0 (0%) |
| E-test clarithromycin sensitive | 2 (5.4%) | 28 (75.7%) |
| Patients (n = 502) | RT-PCR + | RT-PCR − | CLR Resistance Associated Gene(s) | |
|---|---|---|---|---|
| Age | 0–16 (n = 175; 34.86%) | 21 (12%) | 154 (88%) | 3 (14.2%) |
| 17–85 (n = 327; 65.13%) | 80 (24.46%) | 247 (75.54%) | 23 (28.75%) | |
| Gender | Men (n = 218; 43.43%) | 48 (22.01%) | 170 (77.9%) | 11 (24.91%) |
| Women (n = 284; 56.57%) | 53 (18.66%) | 231 (81.34%) | 15 (28.38%) | |
| Total | 101 (20.11%) | 401 (79.89%) | 26 (25.74%) | |
Disclaimer/Publisher’s Note: The statements, opinions and data contained in all publications are solely those of the individual author(s) and contributor(s) and not of MDPI and/or the editor(s). MDPI and/or the editor(s) disclaim responsibility for any injury to people or property resulting from any ideas, methods, instructions or products referred to in the content. |
© 2024 by the authors. Licensee MDPI, Basel, Switzerland. This article is an open access article distributed under the terms and conditions of the Creative Commons Attribution (CC BY) license (https://creativecommons.org/licenses/by/4.0/).
Share and Cite
Pittie, G.; Laurent, T.; Radermacher, J.; Herens, S.; Boeras, A.; Ho, G. Detection by Real-Time PCR of Helicobacter pylori and Clarithromycin Resistance Compared to Histology on Gastric Biopsies. Microorganisms 2024, 12, 2192. https://doi.org/10.3390/microorganisms12112192
Pittie G, Laurent T, Radermacher J, Herens S, Boeras A, Ho G. Detection by Real-Time PCR of Helicobacter pylori and Clarithromycin Resistance Compared to Histology on Gastric Biopsies. Microorganisms. 2024; 12(11):2192. https://doi.org/10.3390/microorganisms12112192
Chicago/Turabian StylePittie, Guillaume, Terry Laurent, Jean Radermacher, Sophie Herens, Anca Boeras, and Giang Ho. 2024. "Detection by Real-Time PCR of Helicobacter pylori and Clarithromycin Resistance Compared to Histology on Gastric Biopsies" Microorganisms 12, no. 11: 2192. https://doi.org/10.3390/microorganisms12112192
APA StylePittie, G., Laurent, T., Radermacher, J., Herens, S., Boeras, A., & Ho, G. (2024). Detection by Real-Time PCR of Helicobacter pylori and Clarithromycin Resistance Compared to Histology on Gastric Biopsies. Microorganisms, 12(11), 2192. https://doi.org/10.3390/microorganisms12112192





